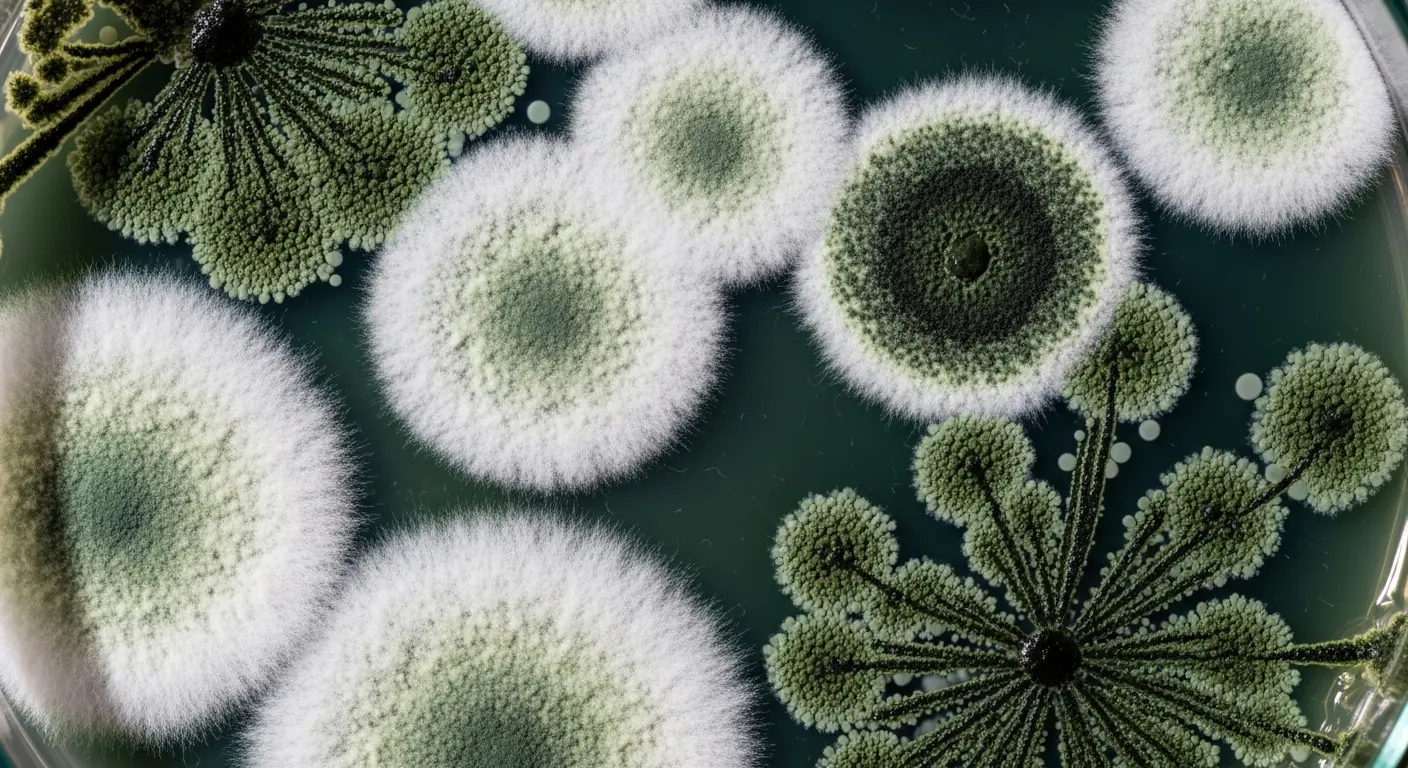

買ってきたかぼちゃを切ったら、種やワタにふわふわした白いものが…。「これってカビ?食べても大丈夫?」と不安になりますよね。その白いものは、危険なカビかもしれませんし、無害なでんぷんかもしれません。この記事では、園芸の専門家が、かぼちゃの種に生えるカビの正体と原因を科学的根拠に基づいて徹底解説します。カビが生えたかぼちゃが食べられるのかという安全性から、カビた種でも発芽させて育てられるのか、家庭でできる種子消毒の方法、さらには来年に向けた正しい種の保存方法や自家採種に関する法律まで、あなたの疑問と不安をすべて解決します。この記事を読めば、もうかぼちゃのカビに悩むことはありません。
- かぼちゃの種のカビとでんぷんの見分け方がわかる
- カビが生えたかぼちゃを食べてはいけない理由がわかる
- カビた種を発芽させるための洗浄・消毒方法がわかる
- カビを防ぐための正しいかぼちゃと種の保存方法がわかる
かぼちゃの種に生えたカビの正体と原因
- その白いものは本当にカビ?でんぷんとの違い
- なぜ?かぼちゃの種にカビが発生する主な原因
- カビが生えたかぼちゃは食べても安全?
- 種類別に見るカビと健康への影響
その白いものは本当にカビ?でんぷんとの違い

かぼちゃを切ったときに見かける白い物質。それがすべて危険なカビというわけではありません。多くの場合、それはかぼちゃ自身の成分である「でんぷん」が結晶化したものです。カビとでんぷんは見た目や発生場所に明確な違いがあるため、慌てずに見分けることが重要です。
まず、最もわかりやすい違いは形状です。カビは菌糸と呼ばれる糸状の構造をしており、綿菓子のように「ふわふわ」とした立体的な見た目をしています。主に水分と栄養が豊富な種やワタの部分を中心に発生します。一方で、でんぷんは白い粉が吹いたような、あるいは膜が張ったような平坦な見た目です。これはかぼちゃが乾燥したり、温度変化にさらされたりすることで、内部のでんぷん質が表面に現れる生理現象です。主に果肉の切り口や皮のすぐ下に見られます。
匂いも判断材料になります。カビの場合は特有のカビ臭さや、腐敗臭、酸っぱい匂いがすることがありますが、でんぷんの場合はほとんど無臭です。この見分け方を知っておくだけで、無駄に美味しいかぼちゃを捨ててしまうことを防げます。
| 特徴 | カビ | でんぷん |
|---|---|---|
| 見た目 | ふわふわした綿状、糸状、立体的 | 白い粉状、結晶状、膜状、平坦 |
| 発生場所 | 主に種やワタの部分 | 主に果肉の切り口や皮の下 |
| 匂い | カビ臭い、酸っぱい匂い、腐敗臭 | ほぼ無臭、かぼちゃ本来の匂い |
| 安全性 | 食用不可、健康被害のリスクあり | 食べても問題ないが、食感が劣る場合がある |
なぜ?かぼちゃの種にカビが発生する主な原因

では、なぜかぼちゃの内部、特に種やワタの部分でカビが発生しやすいのでしょうか。それにはいくつかの条件が重なっています。カビは微生物の一種であり、その繁殖には「水分」「栄養」「温度」そして「酸素」という4つの要素が必要です。かぼちゃの内部は、まさにこれらの条件が揃いやすい環境なのです。
第一に、圧倒的な水分の多さです。かぼちゃのワタと種は、果肉部分に比べて非常に多くの水分を含んでいます。カビの繁殖には水分が不可欠であり、この湿潤な環境がカビにとって絶好の温床となります。
第二に、豊富な栄養源です。ワタには糖質やデンプン質が豊富に含まれており、これらはカビの格好のエサとなります。水分と栄養が揃うことで、カビは爆発的に増殖する力を得ます。
第三に、適切な温度です。多くのカビは20~30℃の環境で最も活発に繁殖します。常温で保存されることが多いかぼちゃは、特に夏場や暖房の効いた室内では、このカビの繁殖適温帯に置かれがちです。
最後に、収穫や流通過程で生じる「傷」も大きな原因です。皮に目に見えないほどの小さな傷がつくと、そこからカビの胞子が内部に侵入し、ワタの部分で繁殖を開始します。これら複数の要因が組み合わさることで、かぼちゃの種にカビが発生するのです。
ELカビが生えたかぼちゃは食べても安全?


もし、かぼちゃの種やワタにカビを確認した場合、そのかぼちゃを食べることはできるのでしょうか。結論から言うと、絶対に食べてはいけません。たとえカビが生えている部分だけを取り除いたとしても、安全とは言えないのです。
その理由は、カビが作り出す「マイコトキシン」というカビ毒にあります。マイコトキシンは非常に毒性が強く、発がん性を持つものや、肝臓や腎臓に障害を与えるものなど、様々な種類が存在します。問題なのは、このカビ毒が非常に熱に強いということです。通常の加熱調理、例えば煮たり焼いたりしたくらいでは、その毒性はほとんど分解されません。
「カビが見える部分だけを捨てれば大丈夫」と考えるのも危険です。私たちが目で見ているふわふわしたカビは、いわば植物の「花」の部分にすぎません。その根にあたる「菌糸」は、目に見えないレベルで果肉の奥深くまで侵入しています。そのため、一見きれいに見える部分にも、すでにカビ毒が広がっている可能性が十分にあるのです。健康へのリスクを考えれば、少しでもカビが確認されたかぼちゃは、残念ですが丸ごと廃棄するのが最も賢明な判断です。
安全のための鉄則
カビの生えた食品は、少量であっても健康に深刻な影響を及ぼす可能性があります。特に、免疫力が低下している方、小さなお子様、高齢者の方は注意が必要です。「もったいない」という気持ちよりも、「安全」を最優先し、食べるのは絶対に避けてください。
種類別に見るカビと健康への影響

かぼちゃに発生するカビには、いくつかの種類があります。最もよく見られるのは、綿のように見える「白カビ」です。その他にも、パンなどにも生える緑色の「青カビ」や、黒いすすのように見える「黒カビ」が発生することもあります。
これらのカビの中には、チーズの製造に使われるような無害なものも存在しますが、食品に自然発生するカビの多くは有害な毒素を産生する可能性があります。例えば、乾燥した環境を好むカワキコウジカビ(ユーロチウム属)や、糖度の高い食品を好むワレミア属のカビなど、様々な種類が家庭環境に存在しています。
重要なのは、これらのカビを家庭で正確に種類まで特定し、その安全性を判断することは不可能に近いということです。見た目だけで「このカビは大丈夫だろう」と判断するのは非常に危険です。カビの種類によって産生する毒素も異なり、アレルギー反応を引き起こす原因になることもあります。
したがって、カビの種類を特定しようと試みるよりも、「食品に意図せず生えたカビは、すべて有害である可能性がある」と認識することが、健康を守る上で最も大切な心構えです。どんな色のカビであっても、発見したらかぼちゃ全体を安全に処分するようにしましょう。
カビが生えたかぼちゃの種の正しい対処法と予防策
- カビた種は発芽する?復活させるための洗浄・殺菌方法
- 家庭でできる種子消毒「温湯消毒」のやり方
- 来年に向けた正しい種の保存方法【自家採種の基本】
- 【重要】自家採種の注意点と種苗法について
- そもそもカビさせない!かぼちゃの正しい保存術
カビた種は発芽する?復活させるための洗浄・殺菌方法


「かぼちゃは食べられないけれど、この種を来年育ててみたい…」そう考えるガーデナーの方もいらっしゃるでしょう。では、カビが生えてしまった種は発芽するのでしょうか。答えは、「可能性はありますが、適切な処置が必要です」です。
多くの場合、種に付着しているカビは表面的なもので、種子の内部(胚)まで侵されていないことがあります。そのため、カビやその栄養源となるワタを徹底的に取り除くことで、発芽能力を復活させられる可能性があります。
まずは、種をワタから丁寧に取り分けます。次に、ザルなどに入れて流水で念入りに洗い、表面のぬめりやワタの残りを完全に除去します。この洗浄作業が最も重要で、カビの温床となる有機物をなくすことが目的です。指で優しくこするようにして、一つ一つの種をきれいにしましょう。
軽い表面のカビであれば、この洗浄だけで十分な場合もありますが、念のため簡単な殺菌処理を行うとさらに安心です。家庭で手軽にできる方法として、薄めたお酢(食酢を水で10倍程度に薄めたもの)に数分間浸してから、再度きれいな水で洗い流す方法があります。これにより、カビの菌の活動をある程度抑制する効果が期待できます。洗浄・殺菌が終わったら、最も重要なのが「完全な乾燥」です。風通しの良い場所で、種がカラカラになるまでしっかりと乾かしてください。
家庭でできる種子消毒「温湯消毒」のやり方


より本格的に種子の病原菌対策を行いたい場合、農家でも行われている「温湯消毒(おんとうしょうどく)」という方法が家庭でも実践可能です。これは、農薬を使わずに熱の力で種子に付着・潜伏している病原菌を殺菌する技術です。目に見えるカビだけでなく、将来「立枯病」などの病気を引き起こす可能性のある微細な菌にも効果があります。
ただし、この方法は温度と時間の管理が非常に厳密で、間違えると種子の発芽能力を完全に失わせてしまうリスクも伴います。挑戦する際は、必ず正確な温度計を用意し、手順を厳守してください。かぼちゃのフザリウム立枯病菌に対しては、一般的に「55℃で15分間」の処理が有効とされています。
この処理は、単にカビを取り除くというレベルを超え、来シーズンの栽培を健全にスタートさせるためのプロの技術です。もし大切な種を確実に育てたいのであれば、挑戦してみる価値はありますが、最初は少数の種で試してみることを強くお勧めします。
家庭でできるカボチャ種子の温湯消毒手順
| 手順 | 作業内容 | ポイント・注意点 |
|---|---|---|
| 1. 準備 | 清潔な種子、精度の高い料理用温度計、鍋2つ(温湯用、冷却用)、ザル、キッチンペーパーを用意する。 | 温度管理が最も重要です。1℃の誤差が成否を分けることがあります。 |
| 2. 種子の洗浄 | 種子をぬるま湯でよく洗い、ワタなどを完全に取り除く。 | 汚れが残っていると消毒効果が均一に行き渡りません。 |
| 3. 温湯処理 | 鍋に湯を張り、55℃を厳密に保つ。種子をザルに入れ、15分間浸漬する。 | 温度が上下しないよう常に確認。高すぎると発芽せず、低すぎると効果がありません。 |
| 4. 冷却 | 処理後、すぐに冷水が入った鍋に種子を移し、完全に冷ます。 | 急速に冷やすことで、種子への熱ダメージを最小限に抑えます。 |
| 5. 乾燥 | キッチンペーパーなどの上で、風通しの良い場所で完全に乾燥させる。 | 湿ったままだと再びカビや腐敗の原因になります。播種直前に行うのが理想です。 |
温湯消毒は非常に効果的ですが、品種や種子の状態によっては発芽率が低下することがあります。大切な種子で実施する前には、必ず少数の種子で予備試験を行い、発芽への影響を確認してください。
来年に向けた正しい種の保存方法【自家採種の基本】


一度カビの問題に直面すると、来年こそは健全な種を保存したいと思うものです。自家採種(じかさいしゅ)した種を正しく保存することは、未来の豊かな収穫への第一歩です。ポイントは「洗浄」「乾燥」「低温・低湿保管」の3つです。
まず、種の「洗浄」です。収穫したかぼちゃの中から、最もよく熟した健康な果実を選びます。種を取り出したら、前述の通り、ワタやぬめりを完全に洗い流します。この一手間が、保存中のカビ発生を劇的に減らします。
次に、最も重要な工程である「乾燥」です。洗浄した種を新聞紙やキッチンペーパーの上に重ならないように広げ、直射日光の当たらない、風通しの良い場所で数週間かけてじっくりと乾燥させます。触ってみてカリッとした感触になり、爪で割れるくらいが目安です。この乾燥が不十分だと、保存中に内部の水分でカビが生えたり、発芽能力が失われたりします。
最後に「低温・低湿保管」です。完全に乾燥した種は、湿気を通さない密閉容器(例:茶筒、海苔の缶、ジップ付き袋)に入れます。この際、お菓子などに入っている乾燥剤(シリカゲル)を一緒に入れると、さらに万全です。容器ごと冷蔵庫の野菜室など、温度変化の少ない冷暗所で保管しましょう。冷凍庫は種子内部の水分が凍って細胞を破壊する可能性があるため、避けるのが一般的です。正しく保存すれば、かぼちゃの種は数年間発芽能力を保つことができます。
【重要】自家採種の注意点と種苗法について


家庭菜園で自家採種を楽しむ上で、知っておくべき大切な法律があります。それが「種苗法(しゅびょうほう)」です。この法律は、新しい品種を開発した人(育成者)の権利を守るためのもので、2022年に改正されました。
まず、野菜の品種には大きく分けて「一般品種(在来種など)」と、法律で保護されている「登録品種」の2種類があります。自家採種に関するルールで注意が必要なのは、後者の「登録品種」です。登録品種を育成者の許可なく、事業として増殖(種を採って増やすこと)したり、譲渡・販売したりすることは法律で禁止されています。
では、家庭菜園ではどうなのでしょうか。結論として、登録品種であっても、個人的に家庭内で楽しむ目的(販売や他人への譲渡をしない)であれば、自家採種して翌年自分の畑で栽培することは、これまで通り認められています。
自分が育てている品種が登録品種かどうかは、購入した種の袋や苗のラベルに「登録品種」や「PVPマーク」といった表示があるかで確認できます。また、F1品種(一代雑種)の種を採っても、親と全く同じ性質のものは育たないため、品質を求めるなら毎年新しい種を購入するのが確実です。法律と品種の特性を正しく理解し、ルールを守ってガーデニングを楽しみましょう。
自家採種のポイントまとめ
- 一般品種・在来種:自由に自家採種してOK。
- 登録品種:家庭菜園で自分で楽しむ範囲なら自家採種OK。ただし、採った種や苗、収穫物を販売・譲渡するのはNG。
- F1品種:自家採種は可能だが、親と同じものは育たないため、品質がばらつく。
そもそもカビさせない!かぼちゃの正しい保存術
種のカビ問題は、元をたどればかぼちゃ本体の保存方法に行き着きます。カビを発生させないためには、かぼちゃを適切な環境で保存することが何よりも大切です。保存方法は「丸ごと」か「カット済み」かで大きく異なります。
【丸ごとの場合】
収穫後のかぼちゃは、直射日光を避け、風通しの良い10℃前後の冷暗所で保存するのが基本です。多くの人がやりがちな間違いが、冷蔵庫に入れてしまうこと。かぼちゃは低温障害を起こしやすく、かえって傷みが早まることがあります。農家では「キュアリング」といって、収穫後に一定期間乾燥させることで、ヘタの切り口をコルク化させ、雑菌の侵入を防ぎ、保存性を高めます。家庭でも、新聞紙にくるんで涼しい玄関や北側の部屋に置いておくと長持ちします。
【カットした場合】
一度包丁を入れたかぼちゃは、カビのリスクが一気に高まります。なぜなら、カビの温床となるワタと種が空気に触れてしまうからです。カットした場合は、



総括:かぼちゃの種のカビは正しく見極め、安全第一の対策を
この記事のまとめです。
- かぼちゃの白い物質は、ふわふわした「カビ」と粉状の「でんぷん」がある。
- カビの発生原因は、主に水分、栄養、温度、傷の4要素である。
- 種とワタは水分と栄養が豊富なため、特にカビが生えやすい。
- カビが産生するカビ毒(マイコトキシン)は加熱しても分解されにくい。
- カビが生えたかぼちゃは、菌糸が内部に広がっているため食用は厳禁である。
- 安全を最優先し、カビを発見した場合はかぼちゃ全体を廃棄すべきである。
- カビた種でも、表面的なものであれば洗浄・殺菌して発芽させられる可能性がある。
- 種の洗浄は、流水でワタやぬめりを完全に除去することが基本である。
- 家庭でできる種子消毒として、農薬不要の「温湯消毒」が有効である。
- 温湯消毒は、55℃で15分など、正確な温度と時間の管理が必須である。
- 自家採種した種の保存は、「完全な洗浄」「徹底的な乾燥」「低温・低湿保管」が原則である。
- 乾燥させた種は、乾燥剤と共に密閉容器に入れ、冷蔵庫で保管するのが理想的だ。
- 種苗法により「登録品種」の無断増殖・販売は禁止されている。
- 家庭菜園での個人的な利用であれば、登録品種の自家採種も認められている。
- 丸ごとのかぼちゃは、風通しの良い冷暗所で常温保存が基本である。
- カットしたかぼちゃは、ワタと種を sofortに取り除き、ラップをして冷蔵保存する。











